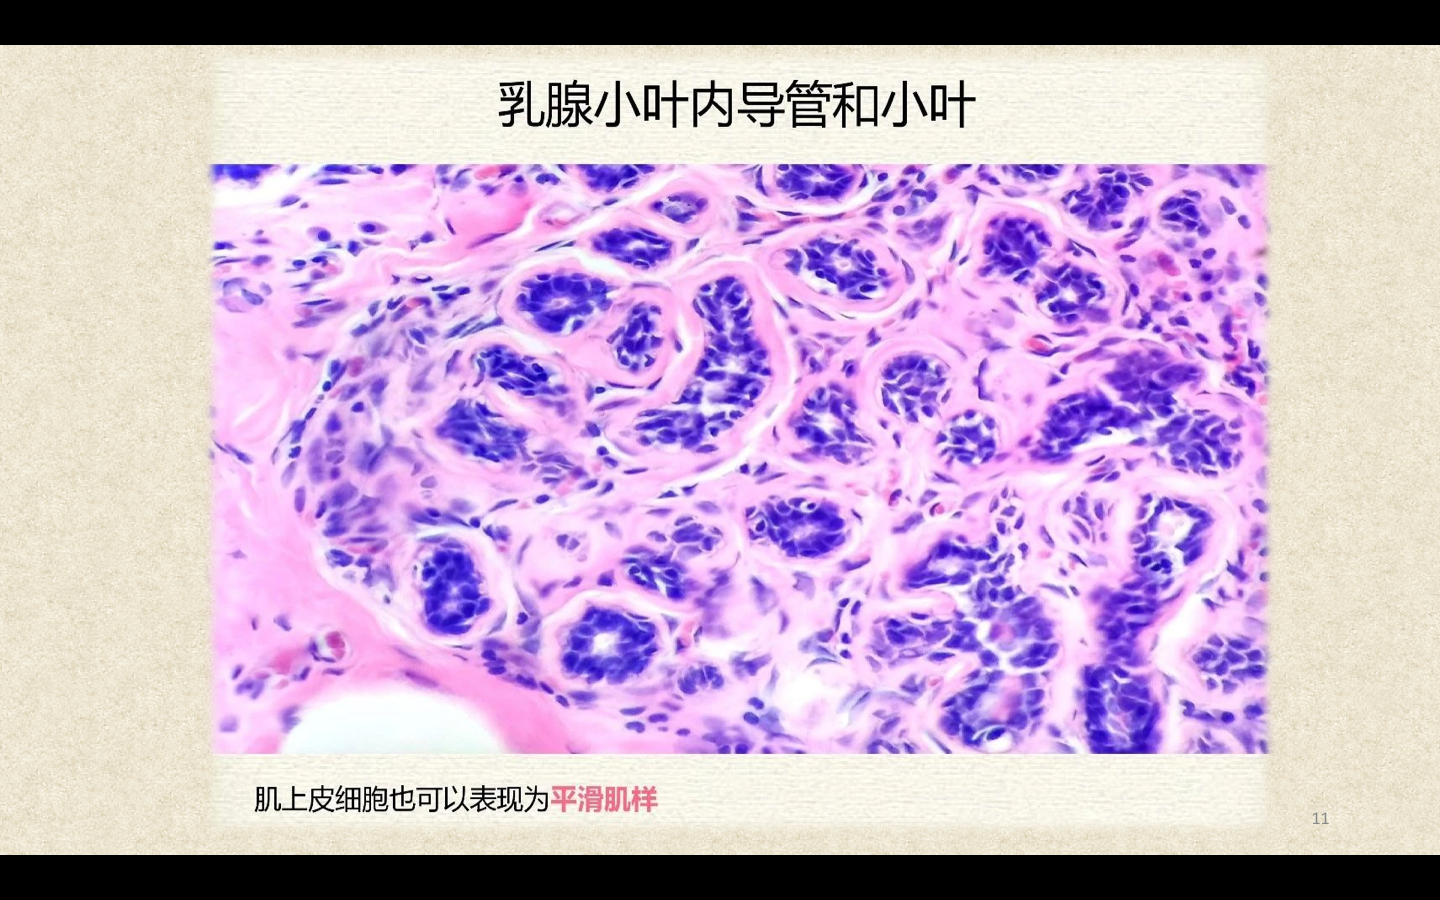

暂无搜索结果
-
1 开启病理学习之旅
-
1.1 视频:《病理学》自适应式教学设计
-
1.2 病理学教材及教学大纲
-
1.3 视频:病理科那些事儿
-
1.4 视频:病理学的研究方法
-
2 第一单元 细胞、组织的适应与损伤
-
2.1 学习目的与要求
-
2.2 第一节 适应
-
2.3 第三节 细胞可逆性损伤
-
2.4 第四节 细胞死亡
-
2.5 临床病理讨论
-
3 第二单元 损伤的修复
-
3.1 学习目的与要求
-
3.2 第一节 再生
-
3.3 第二节 纤维性修复
-
3.4 第三节 创伤愈合
-
3.5 临床病理讨论
-
4 第三单元 局部血液循环障碍
-
4.1 学习目的与要求
-
4.2 第一节 充血和瘀血
-
4.3 第二节 血栓形成
-
4.4 第三节 栓塞
-
4.5 第四节 梗死
-
4.6 临床病理讨论
-
5 第四单元 炎症
-
5.1 学习目的与要求
-
5.2 第一节 炎症的概述
-
5.3 第二节 急性炎症
-
5.4 第三节 慢性炎症
-
5.5 临床病理讨论
-
6 第五单元 肿瘤
-
6.1 学习目的与要求
-
6.2 皮肤的组织学基础
-
6.3 01 肿瘤的概念、形态与结构
-
6.4 02 肿瘤的生长与扩散,分级与分期
-
6.5 03 良 恶性肿瘤鉴别,肿瘤的命名与分类
-
6.6 04 常见肿瘤举例
-
6.7 05 癌前疾病(病变)
-
6.8 06 肿瘤的分子机制
-
6.9 临床病理讨论
-
7 第六单元 心血管系统疾病
-
7.1 学习目的与要求
-
7.2 组织学基础
-
7.3 第一节 动脉粥样硬化
-
7.4 第二节 原发性高血压
-
7.5 第四节 风湿病
-
7.6 第五节 感染性心内膜炎
-
7.7 第六节 心瓣膜病
-
8 第七单元 呼吸系统疾病
-
8.1 学习目的与要求
-
8.2 组织学基础
-
8.3 第一节 呼吸道与肺炎症性疾病
-
8.4 第二节 慢性阻塞性肺疾病(COPD)
-
8.5 第三节 肺尘埃沉着病
-
8.6 第四节 慢性肺源性心脏病
-
8.7 第六节 呼吸系统常见肿瘤
-
9 第八单元 消化系统疾病
-
9.1 学习目的与要求
-
9.2 消化系统组织学基础
-
9.3 第一节 食管的炎症
-
9.4 第二节 胃炎
-
9.5 第三节 消化性溃疡
-
9.6 第四节 阑尾炎
-
9.7 第五节 非特异性肠炎
-
9.8 第六节 病毒性肝炎
-
9.9 第七节 酒精性肝病
-
9.10 第八节 肝硬化
-
9.11 第十二节 消化系统常见肿瘤
-
9.12 章节测验
-
9.13 临床病例讨论
-
10 第九单元 泌尿系统疾病
-
10.1 学习目的与要求
-
10.2 组织学基础
-
10.3 第一节 肾小球肾炎
-
10.4 第二节 肾小管间质疾病
-
10.5 第三节 泌尿系统肿瘤
-
10.6 章节测验
-
11 第十单元 生殖系统与乳腺疾病
-
11.1 学习目的与要求
-
11.2 组织学基础
-
11.3 第一节 子宫颈疾病
-
11.4 第二节 子宫体疾病
-
11.5 第三节 滋养层细胞疾病
-
11.6 第四节 乳腺疾病
-
12 第十一单元 内分泌系统疾病
-
12.1 学习目的与要求
-
12.2 甲状腺组织学基础
-
12.3 垂体疾病
-
12.4 甲状腺疾病
-
12.5 章节测验
-
13 第十二单元 神经系统疾病
-
13.1 学习目的与要求
-
13.2 神经系统细胞及基本病变
-
13.3 感染性疾病
-
13.4 章节测验
-
14 第十三单元 感染性疾病
-
14.1 学习目的与要求
-
14.2 第二节 结核病
-
14.3 章节测验
-
15 病理学实验
-
15.1 病理实验技术
-
15.2 病理实验
-
15.2.1 实验一 细胞的适应、损伤与修复
-
15.2.2 实验二 局部血液循环障碍
-
15.2.3 实验三 炎症
-
15.2.4 实验四 肿瘤
-
15.2.5 实验五 呼吸系统疾病
-
15.2.6 实验六 心血管系统疾病
-
15.2.7 实验七 消化系统疾病
-
15.2.8 实验八 泌尿系统疾病
-
15.2.9 实验十 感染性疾病
-
16 病理学案例库
-
17 趣味病理
-
17.1 一只展翅欲飞的小蝴蝶
-
17.2 海阔凭豚跃
-
17.3 笑脸——三块人体皮肤痣组织标本组成
-
17.4 努力爬行的小蜗牛
-
17.5 春暖花开
-
17.6 锦鲤贺岁
-
17.7 送你一朵小花花 致敬平凡而努力的你
-
17.8 舞动的芭蕾细胞
-
17.9 误入歧途,翅膀被黏住的小飞娥
-
17.10 萌犬闹元宵
-
1
宫颈
-
2
子宫内膜
-
3
输卵管
-
4
卵巢
-
5
胎盘
-
6
乳腺

选择班级